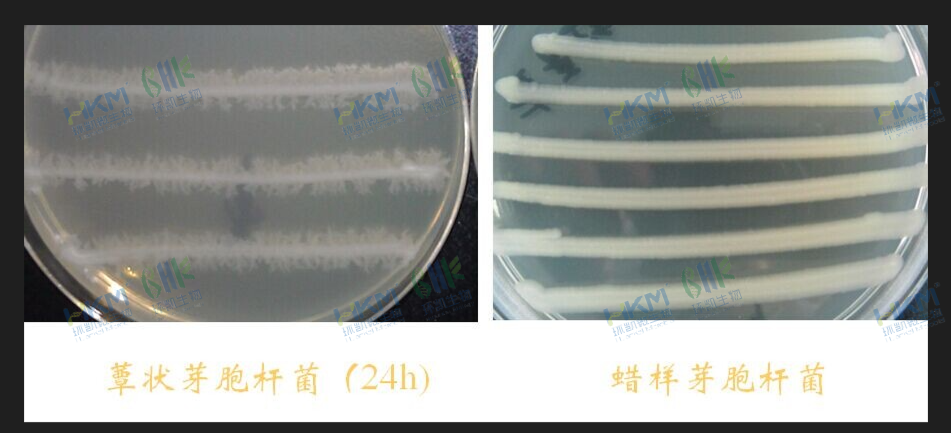
根状实验
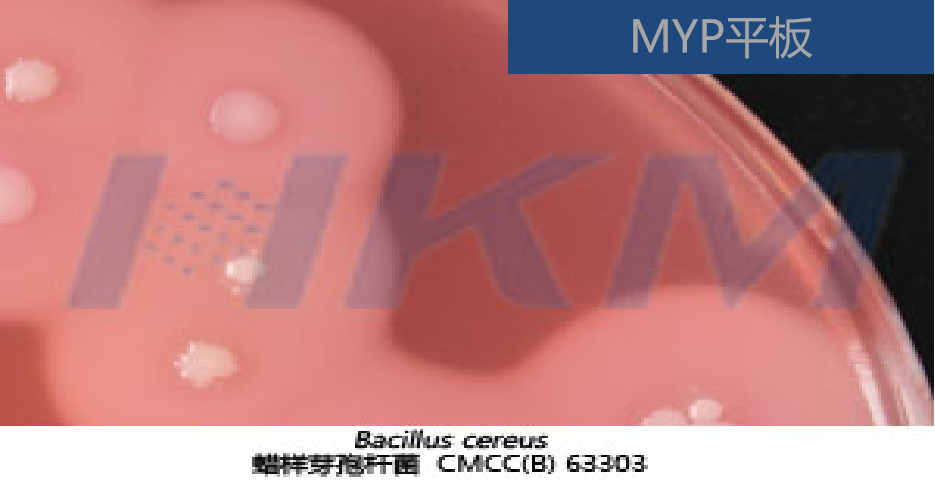
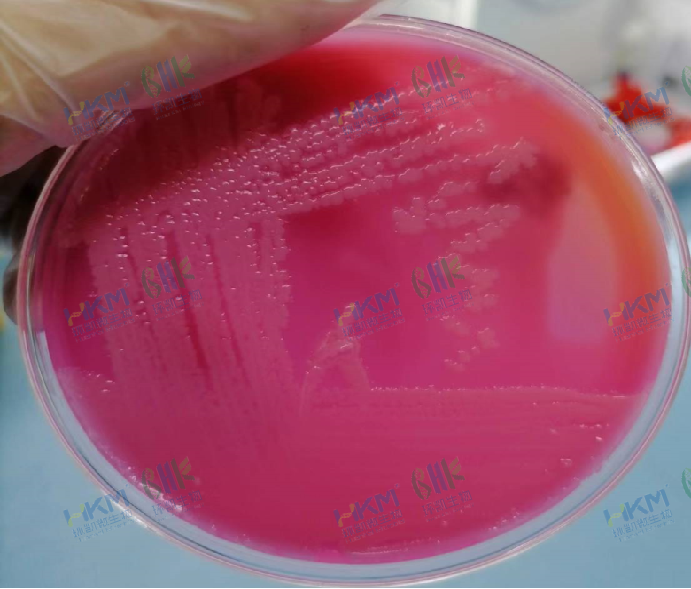
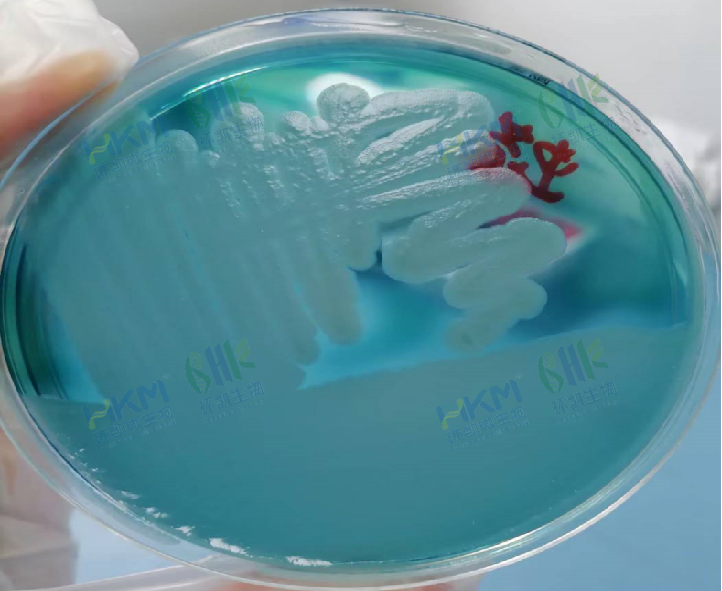
酪蛋白琼脂平板
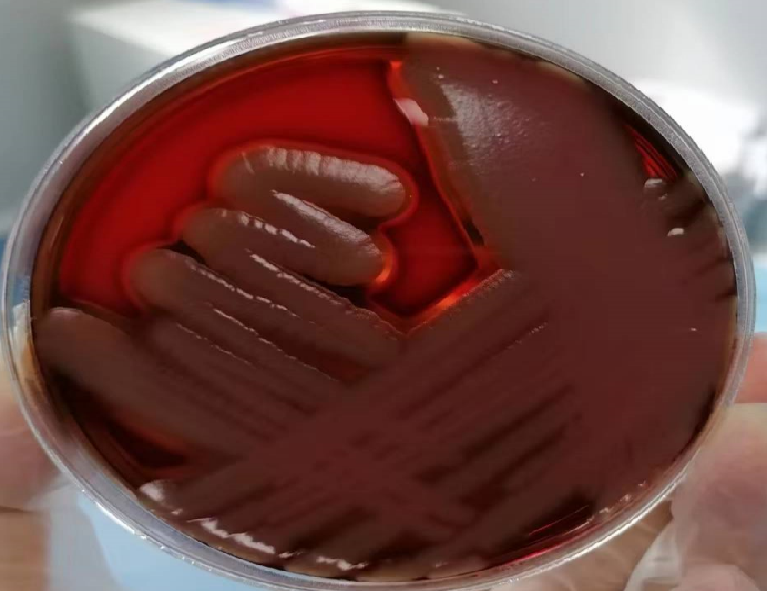
血平板

更新 | GB4789.14-2014 蜡样芽孢杆菌检验及注意事项
发布时间:2024-07-11 浏览次数:5611 分享:
一、蜡样芽孢杆菌检验的卫生学意义
芽胞杆菌科,芽胞杆菌属,革兰氏阳性大杆菌。
● 在自然界分布广泛,常存在于土壤、灰尘和污水中,植物和许多食品中常见
● 已从多种食品中分离出该菌,包括肉、乳制品、蔬菜、鱼、酱油、布丁、米饭及各种甜点。
● 1950年首次在挪威明确报告其致病作用
▶ 引起食物中毒的原因-肠毒素
部分菌株能产生肠毒素,有致呕吐型和腹泻型两类。
◆ 腹泻毒素:大分子量蛋白质,引发腹泻型综合症,能在各种食物中形成;
◆ 呕吐毒素:小分子量、热稳定多肽,100℃ 30min不能被破坏,为引起呕吐型中毒的致病因素,常在米饭中形成。
临床表现:
◆ 腹泻型:潜伏期为8h~16h,主要症状为水泻、腹痛、腹痉挛为主,病程约24h。
◆ 呕吐型:潜伏期为0.5h~5h,症状以恶心、呕吐为主,病程不超过24h。
▶ 蜡样芽胞杆菌食物中毒特征
● 以夏季(6-10月)为主
● 致病因子为细菌繁殖过程中产生的细菌毒素
● 中毒食品含菌量在10的6次方CFU/g(ml)以上
● 引起中毒的原因常为食品食前保存温度不当,放置时间较长或食品加热不当
● 美国 炒米饭
● 欧洲 甜点、肉饼、色拉、奶和肉制品
● 中国 米饭、淀粉类制品
二、蜡样芽孢杆菌的生物学特性
兼性好氧。生长温度范围20~45℃菌落较大,干燥,灰白色,不透明,圆形,凸起,表面粗糙似磨砂玻璃或融蜡状,中等扩散。
10℃以下生长缓慢或不生长。50℃时不生长。
在100℃下加热20min可破坏这类菌。
三、蜡样芽孢杆菌的检验方法
▶ 蜡样芽孢平板计数法检验程序流程

01) 样品的处理
◆ 称取25 g样品至盛有225 mL磷酸缓冲液或0.85%生理盐水的无菌均质杯内,8000 r/min-10000 r/min均质1min-2min,或放入盛有225 mL 稀释液的无菌均质袋中,用拍击式均质器拍打1 min-2 min,制成1:10样品匀液。
02) 液体的稀释
◆ 用1 mL的无菌吸管或微量移液器吸收1:10样品匀液1 mL,加到盛有9 mL磷酸盐缓冲液或0.85%生理盐水的试管中,充分混匀,制成1:100的样品匀液。
◆ 按上一步操作程序,制备10倍系列稀释样品匀液,直至适宜稀释倍数
03) 样品的接种
◆ 选择2-3个适宜稀释度的样品匀液(液体样品可包括原液),单个平行实验中分别吸取0.3 mL、 0.3 mL、 0.4 mL的样品匀液加入MYP琼脂平板,一个稀释梯度两个平行(共6个板),然后用无菌L棒均匀涂布于整个平板。
04) 分离培养
在通常情况下,涂布之后将平皿静置10-30min,待样品匀液吸收后翻转平板,30℃ ± 1℃培养24h。如果培养物的菌落特征不显著,则继续培养至48h。
从符合计数要求的毎个平板中至少挑取5个典型菌落(小于5个全选),划线接种于营养琼脂平板做纯培养,30 ℃±1 ℃培养24 h±2 h。
蜡样芽孢杆菌在MYP琼脂平板上生长的典型菌落为直径2 mm-5 mm,菌落表面粗糙,在深红色背景下呈现粉红色或微粉红色,环绕产生5 mm,宽的卵磷脂酶沉淀环。没有根状生长特性(蕈状芽孢杆菌形成根状生长特征)。
| 酚红为pH指示剂;发酵D—甘露醇产酸使菌落显黄色;卵黄含有卵磷脂,蜡样芽孢杆菌产生卵磷脂酶,在菌落周围产生沉淀环;多粘菌素B可抑制杂菌的生长。 | ![]() |
![]() | |
| MYP琼脂平板划线接种蜡样芽孢杆菌 | MYP琼脂平板涂布接种蜡样芽孢杆菌 |
| MYP琼脂平板接种蜡样芽孢杆菌:微粉红色(表示不利用甘露醇),周围有白色至淡粉色沉淀环(表示产卵磷脂酶) | |
蜡样芽孢显色培养基
|
| 蜡样芽孢杆菌在蜡样芽孢显色培养基平板上生长的典型菌落为直径2 mm-5 mm,菌落表面粗糙,中心蓝绿色,环绕产生5 mm,宽的卵磷脂酶沉淀环。 |
05) 生化鉴定

接种生化鉴定培养基后36±1℃培养18-24h结果
◆ 生化试验:溶菌酶耐性、甘露醇、葡萄糖(厌氧)、淀粉水解、硝酸盐还原、VP试验、明胶、动力、西蒙氏柠檬酸盐。

革兰氏染色
◆ 从每个平板上挑取5个典型菌落,如无典型菌落则挑取可疑菌落。用接种针接触菌落中心部位,分别接种于营养琼脂斜面或平板,30℃ ± 1℃培养24 h,取培养物进行革兰氏染色和证实试验。

1、葡萄糖发酵试验
将培养物接种到糖发酵管中,置于厌氧培养箱中36℃ ± 1℃培养24 h,震荡后肉汤由红变黄,表明在厌氧条件下蜡样芽孢杆菌分解葡萄糖。(也可用液体石蜡形成厌氧环境)。

2、硝酸盐还原实验
将培养物接种到硝酸盐肉汤中,36℃ ± 1℃培养24 h后,加0.25 mL亚硝酸盐试剂A和0.25 mL亚硝酸盐试剂 B,在10 min内变为红色为阳性反应。

3、V-P实验
将培养物接种到改良V-P培养基中,36℃ ± 1℃培养48h或72h后,2ml培养基中添加1mL 5% α-萘酚乙醇溶液,后加入0.4 mL 40% KOH溶液,静置15min出现伊红粉红色为阳性。(注意1:必须在有氧的情况下反应,所以必须充分震摇。2:试剂顺序不能颠倒,可能产生假阳性)

4、酪蛋白分解实验
将培养物接种到酪蛋白琼脂培养基上,36℃ ± 1℃培养48 h,在靠近菌生长的地方培养基为透明的,则表明酪氨酸倍分解,阴性则继续培养至72 h,结果仍为阴性的弃去。
| |
| 酪蛋白分解试验 | 溶血试验 |
![]() | ![]() |
| 酪蛋白琼脂平板 | 血平板 |
| 划线接种蜡样芽孢杆菌:菌落周围培养基出现澄清透明区(表示产生酪蛋白酶) | 划线接种蜡样芽孢杆菌:浅灰色,不透明,似白色毛玻璃状,有完全溶血环 |
5、溶菌酶实验
将培养物接种到0.001%溶菌酶营养肉汤中,另取培养物接种到普通营养肉汤中作对照,36℃ ± 1℃培养24 h,蜡样芽孢杆菌在本培养基中生长,为阳性反应。如出现阴性反应继续培养24 h,结果仍为阴性弃去。

6、触酶试验
在洁净的平皿内滴加3%过氧化氢溶液2滴,用牙签或一次性接种环挑取新鲜培养物放在平皿内过氧化氢溶液中,如果半分钟内发生气泡者为阳性,不发生气泡者为阴性。

7、根状实验
挑取单个可疑菌落划平行直线于经室温干燥1d~2d的营养琼脂平板上,30 ℃±1 ℃培养24 h~48h,不能超过72h。用蜡样芽胞杆菌和蕈状芽胞杆菌标准株作为对照进行同步试验。蕈状芽胞杆菌呈根状生长的特征。蜡样芽胞杆菌呈粗糙山谷状生长的特征。
8、动力试验
用接种针挑取培养物穿刺接种于半固体培养基中,30℃ ± 1℃培养24 h。有动力的蜡样芽孢杆菌沿穿刺线呈扩散生长,而蕈状芽孢杆菌常呈绒毛状生长。

9、溶血试验
将疑似菌点种胰酪胨大豆羊血琼脂平板TSSB,30℃ ± 1℃培养24 h。有动力的蜡样芽孢杆菌会观察到的β-溶血反应。苏云金芽孢杆菌和蕈状芽孢杆菌呈现弱的溶血现象,而炭疽芽孢杆菌通常为不溶血。

10、蛋白质毒素结晶试验

06) 计数方法
选择有典型蜡样芽胞杆菌菌落的平板,且同一稀释度3个平板所有菌落数合计在20 CFU~200CFU之间的平板,计数典型菌落数。如果出现a)~f)现象按公式(1)计算,如果出现g)现象则按公式(2)计算;
a)只有一个稀释度的平板菌落数在20 CFU~200 CFU之间且有典型菌落,计数该稀释度平板上的典型菌落;
b)2 个连续稀释度的平板菌落数均在20 CFU~200 CFU之间,但只有一个稀释度的平板有典型菌落,应计数该稀释度平板上的典型菌落;
c)所有稀释度的平板菌落数均小于20 CFU且有典型菌落,应计数最低稀释度平板上的典型菌落;
d)某一稀释度的平板菌落数大于200 CFU且有典型菌落,但下一稀释度平板上没有典型菌落,应计数该稀释度平板上的典型菌落;
e)所有稀释度的平板菌落数均大于200 CFU且有典型菌落,应计数最高稀释度平板上的典型菌落;
f)所有稀释度的平板菌落数均不在20 CFU~200 CFU之间且有典型菌落,其中一部分小于20 CFU或大于200CFU时,应计数最接近20 CFU或200 CFU的稀释度平板上的典型菌落;
g)2 个连续稀释度的平板菌落数均在20 CFU~200 CFU之间且均有典型菌落。
公式一:
![]() | T----样品中金黄色葡萄球菌菌落数; A---某一稀释度典型菌落的总数; B---某一稀释度鉴定为阳性的菌落数; C---某一稀释度用于鉴定试验的菌落数; d---稀释因子。 |
公式二:
![]() |
| T --- 样品中蜡样芽孢杆菌菌落数; A1 --- 第一稀释度(低稀释倍数)典型菌落的总数; B1 --- 第一稀释度(低稀释倍数)鉴定为阳性的菌落数; C1 --- 第一稀释度(低稀释倍数)用于鉴定试验的菌落数; A2 --- 第二稀释度(高稀释倍数)典型菌落的总数; B2 --- 第二稀释度(高稀释倍数)鉴定为阳性的菌落数; C2 --- 第二稀释度(高稀释倍数)用于鉴定试验的菌落数; 1.1 --- 计算系数; d --- 稀释因子(第一稀释度)。 |
07) 结果与报告
根据MYP平板上蜡样芽胞杆菌的典型菌落数,按4.4中公式(1)、公式(2)计算,报告每g(mL)样品中蜡样芽胞杆菌菌数,以CFU/g(mL)表示;如T值为0,则以小于1乘以最低稀释倍数报告。
必要时报告蜡样芽胞杆菌生化分型结果。
08) 计算范例